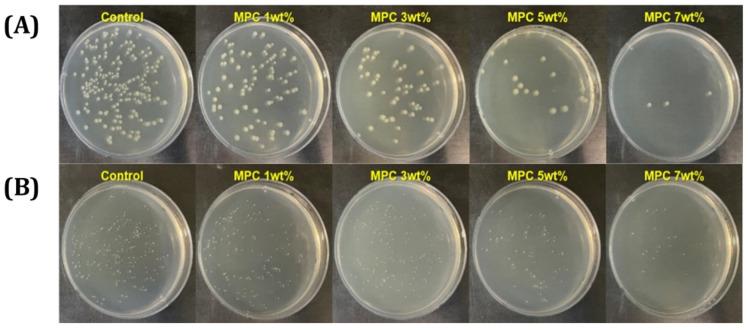
https://cdn.ncbi.nlm.nih.gov/pmc/blobs/abab/12348118/033c86f5b49d/materials-18-03677-g004.jpg

用于牙科修复体数字光处理(DLP)的含抗生物污损两性离子聚合物和二氧化硅/氧化锆填料的树脂复合材料。
Resin Composites with Anti-Biofouling Zwitterionic Polymer and Silica/Zirconia Filler for Digital Light Processing (DLP) of Dental Protheses.
作者信息
Lee Yun-Hee, Jung Jae-Min, Kim Gyu-Nam, Koh Young-Hag
机构信息
School of Biomedical Engineering, Korea University, Seoul 02841, Republic of Korea.
Interdisciplinary Program in Precision Public Health, Korea University, Seoul 02841, Republic of Korea.
出版信息
Materials (Basel). 2025 Aug 5;18(15):3677. doi: 10.3390/ma18153677.
This study aimed to develop an innovative resin composite with anti-biofouling properties, tailored to prosthesis fabrication in dentistry using a digital light processing (DLP) 3D-printing technique. The resin composite was formulated using a blend of dental monomers, with the integration of 2-methacryloyloxylethyl phosphorylcholine (MPC) with anti-biofouling behavior and γ-MPS-treated silica-zirconia powder for simultaneous mechanical reinforcement. The overall characterization of the resin composite was carried out using various contents of MPC incorporated into the resin (0-7 wt%) for examining the rheological behavior, photopolymerization, flexural strength/modulus, microstructure and anti-biofouling efficiency. The resin composite demonstrated a significant reduction in bacterial adhesion (97.4% for and 86.5% for ) and protein adsorption (reduced OD value from 1.3 ± 0.4 to 0.8 ± 0.2) with 7 wt% of MPC incorporation, without interfering with photopolymerization to demonstrate potential suitability for 3D printing without issues ( < 0.01, and < 0.05, respectively). The incorporation and optimization of γ-MPS-treated silica-zirconia powder (10-40 vol%) enhanced mechanical properties, leading to a reasonable flexural strength (103.4 ± 6.1 MPa) and a flexural modulus (4.3 ± 0.4 GPa) at 30 vol% ( = 6). However, a further increase to 40 vol% resulted in a reduction in flexural strength and modulus; nevertheless, the results were above ISO 10477 standards for dental materials.
本研究旨在开发一种具有抗生物污染性能的创新型树脂复合材料,该材料专为牙科修复体制造量身定制,采用数字光处理(DLP)3D打印技术。该树脂复合材料由牙科单体共混物配制而成,集成了具有抗生物污染性能的2-甲基丙烯酰氧基乙基磷酰胆碱(MPC)和用于同时进行机械增强的γ-MPS处理的二氧化硅-氧化锆粉末。使用掺入树脂中的不同含量的MPC(0-7 wt%)对树脂复合材料进行全面表征,以研究其流变行为、光聚合、弯曲强度/模量、微观结构和抗生物污染效率。当MPC掺入量为7 wt%时,树脂复合材料的细菌粘附显著降低( 时为97.4%, 时为86.5%),蛋白质吸附减少(OD值从1.3±0.4降至0.8±0.2),且不干扰光聚合,表明其在3D打印方面具有潜在适用性且无问题(分别为 <0.01和 <0.05)。γ-MPS处理的二氧化硅-氧化锆粉末(10-40 vol%)的掺入和优化提高了机械性能,在30 vol%( = 6)时产生了合理的弯曲强度(103.4±6.1 MPa)和弯曲模量(4.3±0.4 GPa)。然而,进一步增加到40 vol%会导致弯曲强度和模量降低;尽管如此,结果仍高于牙科材料的ISO 10477标准。